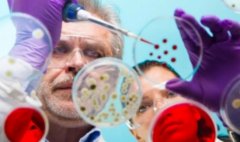
千万注意！这三类人群不能做试管

女性不孕

-
 输卵管通液不能怀孕,但可以作为辅助治疗手段
输卵管通液不能怀孕,但可以作为辅助治疗手段输卵管是女性生育的重要管道,它是卵子从卵巢到子宫的通道,也是受精卵的宫内转移的路径。因此输卵管的健康状况对女性怀孕至关重要。那么输卵管通液可以怀孕吗? 输卵管通液可以怀孕吗
作者:木易 123 发布时间:2026-04-14 -
 正规机构保存一年受精卵需要多少钱?
正规机构保存一年受精卵需要多少钱?女性可以通过冷冻卵子来保存生育力,同时试管用剩下的受精卵其实也可以通过冷冻的方式保存起来。一般只要是正规的医院,都可以提供冷冻服务。只是大家需要注意的是,冷冻费用要比冷
作者:盼盼 177 发布时间:2026-04-14 -
 amh指标低的原因是什么,如何解决amh指标低的问题
amh指标低的原因是什么,如何解决amh指标低的问题一些女性发现自己久备不孕时,就会去医院进行检查,而amh检查作为必检的一个项目,能很好的反映出卵巢的功能,加上检查流程也比较简单,只需要抽适量的血即可,不需要空腹也没有时间
作者:木易 118 发布时间:2026-04-14 -
 amh指标偏高有什么影响?amh指标偏高会阻碍怀孕吗
amh指标偏高有什么影响?amh指标偏高会阻碍怀孕吗一些女性可能做过amh检查,知道amh水平偏低就说明卵巢储备能力较弱,会影响生育力,就希望自己的amh水平越高越好,其实不是这样的,amh是评估卵巢功能的指标,是有参考范围的,如果不在
作者:木易 142 发布时间:2026-04-14 -
 做完试管移植吃什么东西好?建议多吃这些食物
做完试管移植吃什么东西好?建议多吃这些食物试管移植后的饮食安排一览,这4种有助于胚胎着床的食物要多吃,大家都知道,胚胎移植是试管疗程中的最后一个步骤,而这一环节关系到胚胎能否着床。一般来说,女性在移植后是需要做好
作者:木易 174 发布时间:2026-04-14 -
 试管短方案成功率受什么影响?这些方法有助于提高成功率
试管短方案成功率受什么影响?这些方法有助于提高成功率在试管取卵之前,女性会先进行促排。主要就是为了增加卵子的数量从而增加试管成功的几率。女性可以选择的促排方案也有很多种,短方案在临床上的应用是比较广泛的,主要适用
作者:木易 177 发布时间:2026-04-14 -
 什么是试管d2聚体检查,聚体高能不能移植?
什么是试管d2聚体检查,聚体高能不能移植?试管d2聚体检查要重视,d2聚体高对试管的影响可真不小,d2聚体主要是检测凝血功能是否有异常,因此很多女性在做试管之前都会在医生的要求下进行这一检查,而d2聚体是判断凝血常规的一个
作者:木易 164 发布时间:2026-04-14 -
 试管风湿免疫检查有哪三大项目,没有异常才能做试管
试管风湿免疫检查有哪三大项目,没有异常才能做试管风湿免疫检查的三大项目一览,影响试管着床真不是空穴来风,众所周知,试管额并不是人人都能做的,因此很多夫妻在开展试管疗程之前都需要做一个全面的检查,然后在没有异常的情
作者:木易 166 发布时间:2026-04-14 -
 收藏!女性不孕不育通常有这四个前兆
收藏!女性不孕不育通常有这四个前兆在备孕期间,男性精子质量的好坏决定了女性能否顺利怀孕并生下宝宝,对于不孕不育的家庭而言,虽然男性精子质量会影响生育,但是女性如果患有妇科疾病,同样也是导致不孕不育的原因
作者:盼盼 76 发布时间:2026-04-14 -
 女性避孕小妙招赶紧收藏!民间流传方法不靠谱
女性避孕小妙招赶紧收藏!民间流传方法不靠谱民间流传着事后不吃药的避孕秘诀,即“同房后蹲半小时避孕方法”,其实蹲半小时避孕方法的是没有用的,因为精子本人具有游动性,并不会因为身体体位发生改变就会出来,只能缓解精子
作者:盼盼 200 发布时间:2026-04-14 -
 不排卵的‘小信号’提前get,及时就诊不迷路!
不排卵的‘小信号’提前get,及时就诊不迷路!在现实生活中,刚结婚的夫妻,计算好排卵期,积极备孕,但是长时间自然怀孕无果,检查后发现原来是不排卵所引起的,女人不排卵或存在排卵障碍会严重影响生育能力,而不排卵的症状主
作者:wednesday 69 发布时间:2026-04-14 -
千万注意!这三类人群不能做试管
千万注意!这三类人群不能做试管随着社会的发展,医疗技术不断提高,包括试管在内的各种辅助生殖技术也频频出现。大家对试管这个概念已经渐渐的不再陌生,这是目前最常见的治疗不孕不育的方法,已经为很多
作者:盼盼 50 发布时间:2026-04-14
